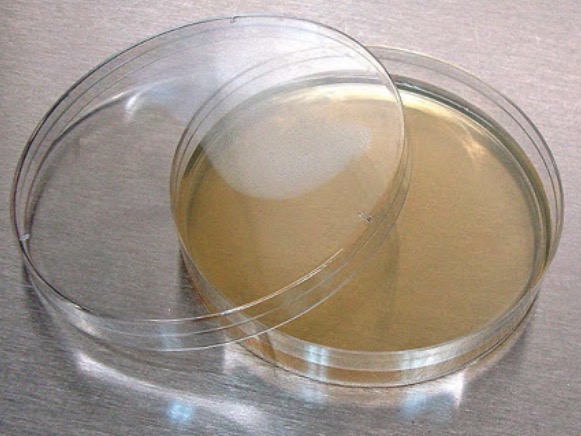
agar

Virology
Bacteriophage
A bacteriophage, also known informally as a phage, is a virus that infects and replicates within bacteria and archaea. The term was derived from "bacteria" and the Greek φαγεῖν, meaning "to devour".

Tags:
Source:
Virology
Bacteriophage Population
There are more than 1030 bacteriophages in the world's waters.
A bacteriophage weighs about 10-15 grams. Therefore the biomass of all bacteriophages on Earth exceeds the biomass of all elephants 1000 fold.
The length of a head to tail line of all 1030 bacteriophages is 100 million light years.
There are more viruses in a liter of sea water than there are people on Earth.
Viruses outnumber cellular life by at least 10:1.

Tags:
Source:
Virology
Sources of Viruses
Whales are one of the most prolific producers of viruses on the planet. They each excrete about 1013 viruses per 1 gram of feces per day.

Tags:
Source:
Virology
Viruses Abundance

Tags:
Source:
Virology
HIV Genome
There are about 1016 HIV genomes on the planet.
Tags:
Source:
Virology
Herpes Virus in Humans
Every human is infected with some kind of a herpes virus. This infection is for life. We get most of them young from our parents.
Tags:
Source:
Virology
Human Virome Definition
The human virome is the total collection of viruses in and on the human body.
Tags:
Source:
Virology
Human Virome Population
67.7% of DNA sequences found in human blood are viral.

Tags:
Source:
Virology
Human Genome
Human genome consists of 3.2 billion bases. Only 1.5% of them print proteins (about 20-30 thousand proteins).
Tags:
Source:
Virology
Pathogen/Pathogenic Definition
(of a bacterium, virus, or other microorganism) causing disease.
In biology, a pathogen in the oldest and broadest sense, is anything that can produce disease. A pathogen may also be referred to as an infectious agent, or simply a germ.
Tags:
Source:
Virology
Most Viruses Pass Trough Us
Most viruses pass through us without harming us.
A study showed that 91% of viruses in human feces resembled plant viruses.
Many viruses are beneficial for us.
Tags:
Source:
Virology
Most Abundant Fecal Virus
The most abundant human fecal virus is pepper mild mottle virus contained in pepper.
Tags:
Source:
Virology
Metagenomics
Metagenomics is the study of genetic material recovered directly from environmental samples.
Tags:
Source:
Virology
Viruses Evolve with Their Hosts
Viruses evolve with their hosts (including people) over the ages. Migration patterns of different groups of people around the world can be tracked by studying their viruses.
The dotted line shows migration of humans out of Africa tracked via the human genome sequence. The solid line shows the same based on virus tracking (gives more detail).

Tags:
Source:
Virology
Virus Definition
An infectious, obligate intracellular parasite comprising genetic material (DNA or RNA) surrounded by a protein coat and/or a membrane.
Tags:
Source:
Virology
Virus Definition
An infectious, obligate intracellular parasite comprising genetic material (DNA or RNA) surrounded by a protein coat and/or a membrane.
Infections means it has to go infect the host. Obligate intracellular parasite means it has to get inside the host's cell to multiply. Parasite means that it causes some damage to the host.
Tags:
Source:
Virology
Viruses and RNA
Viruses are the only RNA based life form we know about.
Tags:
Source:
Virology
Virion
Infectious virus particle. Not all virus particles are infections. Viruses as a culture are not 100% effective.
Tags:
Source:
Virology
Virus Sizes
Most viruses are about 200nm or smaller. A class of viruses called mimiviruses were recently discovered. Those are 2um in diameter with a huge DNA strand inside.

Tags:
Source:
Virology
Virus Replication
Viruses do not replicate via binary fission line cells. They invade host cells, start fabricating parts (the eclipse period) and then rapidly assemble new viruses from these parts (the burst or yield period). For this reason, the growth curve of viruses and cells look different.

Tags:
Source:
Virology
Retrovirus
A retrovirus is a type of RNA virus that inserts a copy of its genome into the DNA of a host cell that it invades, thus changing the genome of that cell.
Tags:
Source:
Virology
Virus Age
The oldest known retroviruses are 450 million years old. Some believe viruses originated before cellular life billion+ years ago.
Tags:
Source:
Virology
Variolation
Variolation or inoculation was the method first used to immunize an individual against smallpox (Variola) with material taken from a patient or a recently variolated individual and transmitted to another person, in the hope that a mild, but protective, infection would result.
Tags:
Source:
Virology
Antonie van Leeuwenhoek (1632-1723)
The first person to see microorganisms.
Tags:
Source:
Virology
Robert Koch (1843-1910)
Developed the germ theory of disease.
Tags:
Source:
Virology
Virus Discovery
Viruses were discovered when tabacco plants were infected with what was thought were bacteria. The scientists ground up the leaves and filtered the fluid through a filter with the hope to contrate the bacteria on the filter. Instead, they found out that applying the bacteria condensed on the filter to healthy tabacco plants didn't infect them. Rather, it was the liquid that went through the filter that infected them. They figured the liquid contains some agent, they called virus, that causes the disease.

Tags:
Source:
Virology
Virus Replication
All viruses must make mRNA that can be translated by host's ribosomes: They are all parasites of the host protein synthesis machinery.
Tags:
Source:
Virology
Infectious Cycle
The life cycle of a virus infecting a cell. Consists of 5 main phases: 1. Attachment and entry 2. Translation 3. Genome replication 4. Assembly 5. Release.

Tags:
Source:
Virology
Susceptible Cell
A cell with a functional receptor for a given virus. The cell may or may not be able to support viral replication.
Tags:
Source:
Virology
Resistant Cell
A cell with no receptor. It may or may not be able to support viral replication.
Tags:
Source:
Virology
Permissive Cell
The cell has the capacity to replicate a virus. It may or may not be susceptible for it, though. Even if the viral genome gets inside the cell, the cell has to be permissive to be able to replicate the viral genome.
Tags:
Source:
Virology
Susceptible and Permissive Cell
The only type of a cell that take up a virus particle and replicate it.
Tags:
Source:
Virology
Early Virus Replication in Labs
In the early days of virology, scientists were not able to replicate viruses in cultured cells. Instead, they propagated viruses in laboratory animals.
Tags:
Source:
Virology
Chicken Eggs as Virus Incubators
In the early days of virology, embryonated chicken eggs were common to replicate viruses. This method is still used for the influenza viruses today. It's much easier to grow viruses in eggs than in cell cultures on scale. Eggs are sterile, enclosed, large incubators.
Tags:
Source:
Virology
Human Cell Cultures as Virus Incubators
Enders, Weller, and Robbins were scientists in the 1950's who were first able to grow the polio virus in human cell cultures. They received the Nobel Prize for it. Since then, most viruses are grown in cell cultures.
Tags:
Source:
Virology
Cell Cultures
Primary human foreskin fibroblasts are used as cell cultures to replicate viruses. The difficulty with them is that the cells don't replicate indefinitely. Their telomeres shorten over generations and the culture dies.
Mouse fibroblast cell line (3T3) and human epithelial cell line (HeLa) replicate indefinitely, so those are preferable as cell cutlures for virus replication. They are not genetically a good fit for some viruses and some research objectives, though.
Tags:
Source:
Virology
Diploid Cell Strains
A cell culture line used for virus replication that is in between primary human foreskin fibroblasts and mouse fibroblast cell line in terms of pros and cons.
Tags:
Source:
Virology
Fibroblast
A fibroblast is a type of biological cell that synthesizes the extracellular matrix and collagen, produces the structural framework (stroma) for animal tissues, and plays a critical role in wound healing. Fibroblasts are the most common cells of connective tissue in animals.

Tags:
Source:
Virology
Cytopahtic Effect
The destructive effect that viruses inflict on cells. The effect is observable in a microscope. One such effect is cell detachment and rounding before death. Another is the formation of syncytia.

Tags:
Source:
Virology
Formation of Syncytia
A cytopathic effect where the infected cells fuse forming a blob (syncytium) and die.

Tags:
Source:
Virology
Infectivity
Virus sample's ability to infect cells.
Tags:
Source:
Virology
Infectivity: Plaque Assay
In 1952, Renato Dulbecco developed plaque assay for animal viruses. Take a tube of viruses, dilute it 1/10 a few times over, infect a cell culture with 0.1 ml of the diluted sample and observe plaque formation (spots). If too many, dilute again 1/10, infect, observe spots. Keep repeating until spots are easy to count. Then multiply by the spot count by 10n where n is the number of 1/10 dilutions. You get the infectivity of the original sample per 0.1 ml of volume in plaque forming units per ml (PFU/ml).

Tags:
Source:
Virology
Virus Infecting Cell Culture
A time lapse of a single monolayer of cell culture infected by a virus in time.
Tags:
Source:
Virology
Lysis
Disintegration of a cell by rupture of its membrane.
Tags:
Source:
Virology
Agar
A gelatinous substance obtained from various kinds of red seaweed and used in biological culture media and as a thickener in foods.
Tags:
Source:
Virology
One Hit Kinetics
Most viruses follow one hit kinetics, meaning a single virus can infect the host cell.
Tags:
Source:
Virology
Two Hit Kinetics
Some viruses follow two hits kinetics, meaning two viruses are needed to infect a host cell. This is because the viral genome is packaged in two viruses and both genomes have to be delivered to the host cell for infection to occur.
Tags:
Source:
Virology
Measurement of Number of Viruses Needed for Infection
A concentration of viral substance is gradually increased in steps and introduced to a cell culture. Then the number of plaques (spots) formed is counted. The concentration and the number of plaques are plotted on a chart. If the data follow a linear fit, the virus follows one hit kinetics (single virus infects). If the data fit x^2 curve, the virus follows two hit kinetics (two viruses infect).

Tags:
Source:
Virology
Plaque Purification
A virus is introduced to a cell assay. When it forms plaque (spots), virus samples are extracted from those spots using a pipette. This process is usually repeated three times to clone a virus that way. Used to isolate virus from original sample, such as an animal or plant.

Tags:
Source:
Virology
Endpoint Dilution Assay
When virus doesn't form a plaque (spots) in the locations of infected cells, a technique called endpoint dilution assay can be used to asses the infectivity of the virus. Cells are placed in rows of tubes and each row is infected with a 1/10 dilution of the virus compared to the previous row. In the end, it's observed what row has about 50% of cells killed across all its tubes. That virus diluation is the one that results in 50% infection. That level of virus concentration is also referred to as TCID50.

Tags:
Source:
Virology
Plaque-forming Unit (PFU)
A plaque-forming unit is a measure used in virology to describe the number of virus particles capable of forming plaques per unit volume.
Tags:
Source:
Virology
Particle-to-PFU Ratio
Number of physical particles / number of infectious particles. Not all viral particles are infectious. A single particle can initiate an infection, but not all viruses succeed at it.
Tags:
Source:
Virology
Virus Growth
Viruses grow in phases: The eclipse period and the burst period. During the eclipse period, viruses genomes are replicating inside cells and viral particles are being assembled. During the burst period, the viral particles are being released from the cells. The latent period is the delay between the onset of the burst phase and the time at which the first viral particles can be detected outside the cells.

Tags:
Source:
Virology
Adsorbing
The process of adding a virus to a cell and making it "stick" to the cell.
Tags:
Source:
Virology
Single vs Multi-step Growth Cycle
The left chart shows virus growth cycle when all cells are infected. The right chart when a subset of the population is infected and a second wave of infection occurs after initial burst.

Tags:
Source:
Virology
Bacterial Growth
Bacteria grow by binary fission. Therefore, they replicate exponentially in time. Viruses don't follow this replication pattern because of the eclipse and burst period phases.

Tags:
Source:
Virology
Multiplicity of Infection (MOI)
The number of infectious particles added per cell. 107 virus particles per 106 cells results in MOI=10. Not every cell receives 10 particles. The distribution follows Poisson distribution. High MOI leads to single step virus growth. Low MOI leads to multi-step growth.
Tags:
Source:
Virology
Calculation of Fraction of Cells Infected by Virus Particles
The following formula determines the fraction of cells infected by k particles.

Tags:
Source:
Virology
Hemagglutination
The influenza virus binds to sugar. Sugar is present on red blood cells, therefore the influenza virus binds to red blood cells. When enough of these cells have the virus attached, the neighboring cells start sticking together forming a lattice. This can be used to measure the number of infectios particles (assay) present in a solution of red blood cells. It does not say anything about the virus' infectivity.

Tags:
Source:
Virology
Reverse Transcriptase (RT)
An enzyme that converts mRNA to DNA.
Tags:
Source:
Virology
Antigen Assay
A type of an assay that can be run in an office or even at home (over-the-counter pregnancy tests use this technology). The presence of the virus is detected when the viral antigens attach to the row of antibodies at the end. The antigens get colored along the way (using colloidal gold, for example) so that when they bind to the antibodies, they are observable as a colored line.

Tags:
Source:
Virology
Fluorescent Protein Tracking
The green fluorescent protein was obtained from the jellyfish and its genome encoding used in virology to be included in the virus' genome to encode fluorescent proteins for tracking purposes using high resolution microscopy. These days, we use multiple color trackers. This technique is so advanced these days that we can use it to track individual viral particles.
Tags:
Source:
Virology
Green Fluorescent Protein
Green fluorescent protein is used for viral particle tracking as well as neuronal connections tracing. This image depicts how the presence of the glowing virus maps out the cell's neoronal connections.

Tags:
Source:
Virology
Polymerase Chain Reaction (PCR)
A technique used to amplify a small amount of DNA to a very large amount of DNA for studying purposes. It requires a thermostable DNA polymerase, which originally came from a bacterium found in the Yellowstone hot springs.
Tags:
Source:
Virology
Polymerase Chain Reaction (PCR) Process
1. Denature sample DNA, 2. Anneal it, 3. Elongate it. Repeat many times (for example 40 times) to get millions or billions of copies of the DNA.

Tags:
Source:
Virology
DNA Denaturation
The process of melting of double-stranded DNA to produce two single strands.

Tags:
Source:
Virology
DNA Annealing
Complementary sequencing of a single-stranded DNA or RNA to pair by hydrogen bonds to form a double-stranded polynucleotide.

Tags:
Source:
Virology
PCR Test Virus Infection Detection
PCR test is not always accurate for detection whether or not an organism is still infected with the virus because PCR is usually done on an RNA sample of the virus, not the entire virus genome. The virus might no longer be infectious.
Tags:
Source:
Virology
Zoonotic Diseases
Diseases that can be transmitted between animals and people.
Tags:
Source:
Virology
Alfred Hershey & Martha Chase 1952 Experiment
These two scientists ran one of the most breakthrough experiments in history of virology. They labeled viral DNA with a radioactive phosphorus and let the virus infect a culture of cells. Many of the next generation cells had the the radioactive DNA in them (not all because some progeny undergoes new DNA synthesis). Then they labeled the virual protein (shell) with a radioactive sulfur instead and repeated the experiment. No viral progeny was radioactive. These results confirmed that DNA is the genetic information passed between generations of viruses.

Tags:
Source:
Virology
7 Viral Genomes
There are thousands of different virions, seemingly infinite complexity of infections, but only 7 different viral genome types.
Tags:
Source:
Virology
The Baltimore System
Knowing only the nature of the viral genome, one can use the Baltimore system to deduce the basic steps that must take place to produce mRNA, which is necessary for viral replication.

Tags:
Source:
Virology
The 7 Classes of Viral Genomes
ds = double stranded, ss = single stranded

Tags:
Source:
Virology
DNA Structural Diversity
DNA and RNA come in various structural forms.

Tags:
Source:
Virology
History of RNA/DNA
Theory goes that originally, there was the RNA world. DNA evolved later. RNA was more susceptible to breaking and errors if the strand got long. After RNA world, there came RNA world with proteins. From that, the DNA world evolved. Today, only the viral genome is left from the RNA world.
Tags:
Source:
Virology
Viroid
First pieces of circular RNA that don't encode any protein. They were very likely the first replicating molecules.
Tags:
Source:
Virology
Main 7 Virus Families and Their Genome Type

Tags:
Source:
Virology
Information Encoded in Viral Genome
1. Replication mechanism of the viral genome.
2. Assembly and packaging.
3. Regulation and timing of the replication cycle.
4. Modulation of the host defenses (tricking the immune system).
5. Spread to other cells.
Tags:
Source:
Virology
Biggest and Smallest Viruses
Viroid genome has 120 base pairs and encode no protein at all. Hepatitis delta satellite has 1700 base pairs and encodes one protein. The largest known is Pandoravirus salinus with 2.4 million base pairs encoding 2500 proteins.
Tags:
Source:
Virology
Adenoviruses
A family of common viruses carrying double stranded DNA. They are common causes of fever, coughs, soar throat, diarrhea, pink eye.

Tags:
Source:
Virology
Herpesviruses
A family of double stranded DNA viruses causing different types of herpes infections.

Tags:
Source:
Virology
Papillomaviruses
A family of double stranded DNA viruses most often causing skin infections without triggering a strong immune response. A natural infection provides a small protection against reinfection.

Tags:
Source:
Virology
Polyomaviruses
A family of double stranded viruses whose natural hosts are primarily mammals and birds.

Tags:
Source:
Virology
Poxviruses
A family of double stranded viruses. Humans, vertebrates, and arthropods serve as natural hosts.

Tags:
Source:
Virology
Double Stranded DNA to mRNA
Double stranded DNA is the only molecule that can be directly transcribed to mRNA.
Tags:
Source:
Virology
Small Viruses and Polymerase
Small viruses (5 kbp) don't encode their own polymerase, they use the one provided by the host cell. Larger viruses (120+kbp)encode their own polymerase.
Tags:
Source:
Virology
Gapped Double Stranded DNA Virus Replication
These viruses' DNA get injected into the cell's nucleus where they get "fixed" by the cells enzyme to become fully double stranded DNA. Then they get transcribed to mRNA. The mRNA then serves as a template for protein synthesis.
Tags:
Source:
Virology
Single Stranded DNA Virus Replication
These viruses' DNA get injected into the cell's nucleus where they get "fixed" by the cells enzyme to become fully double stranded DNA. Then they get transcribed to mRNA. The mRNA then serves as a template for protein synthesis.
Tags:
Source:
Virology
Double Stranded RNA Virus Replication
These viruses cannot use the cell's polymerase enzymes to turn their genome into a double stranded DNA because host cells don't have the mechanism to do it. Therefore, these viruses have to package the RNA polymerase in the virus particle.
Tags:
Source:
Virology
Single Stranded RNA Virus Replication
These viruses don't need the cells polymerase enzymes at all. The cell's ribosomes attach to the RNA directly and start synthesizing proteins. Therefore, these viruses have just a shell and the single stranded RNA in it.
Tags:
Source:
Virology
Reverse Transcriptase
An enzyme used to generate complementary DNA from an RNA template, a process termed reverse transcription.
Tags:
Source:
Virology
Reassortment: Consequence of Segmented Genome
A segmented DNA genome viruses allow for much greater genetic variation. For example, two different influenza viruses from different strains contain distinct segmented genome. When they both infect a cell, the segmented genome injected by both into the cell gets recombined in the process of synthesis of new viruses. These new viruses contain a reassorted genome from the pool of available RNA segments. This reassortment leads to rapid genomic variation.

Tags:
Source:
Virology
Genome Lewis Structure
RNA is often drawn as a squiggly line. In reality, the Lewis stem diagram is a better representation of the so-called secondary structure of the genome. Different parts of the genome bind to other parts dictating the form of the higher order structure.

Tags:
Source:
Virology
Plasmid
A plasmid is a small, extrachromosomal DNA molecule within a cell that is physically separated from chromosomal DNA and can replicate independently. They are most commonly found as small circular, double-stranded DNA molecules in bacteria.

Tags:
Source:
Virology
Transfection
In modern days, we create new viruses with new genomes by synthesizing the desired DNA or RNA, injecting it into bacterial plasmids and mass produce the virus within bacterial cells this way. This process is called transfection.

Tags:
Source:
Virology
Discovery of Influenza
The influenza virus was first identified in 1933.
Tags:
Source:
Virology
NSABB: National Science Advisory Board for Biosecurity
It's a federal advisory committee to provide advice, guidance, and leadership regarding biosecurity oversight of dual use research to all Federal departments and agencies with interest in life sciences research.
Tags:
Source:
Virology
Dual Use Meaning
The National Science Advisory Board for Biosecurity considers dual use research to be an area of research that could be used for good as well as nefarious purposes.
Tags:
Source:
Virology
Subunit
Single folded polypeptide chain.

Tags:
Source:
Virology
Structural unit (protomer, asymmetric unit)
Units from which capsids or nucleocapsids are built. Structural units are made of one or more subunits.
Tags:
Source:
Virology
Capsid
The shell of a virus protecting the enclosed genetic material.

Tags:
Source:
Virology
Nucleocapsid
Similar to capsid, but this term is used for a structure that encloses genetic material, but is itself enclosed by higher structure, such as the envelope.
Tags:
Source:
Virology
Envelope
Host cell derived lipid layer. Viruses never encode their own envelopes. They use one provided by the host cell.

Tags:
Source:
Virology
Virulence
The pathogen's ability to infect or re-infect a host.
Tags:
Source:
Virology
Metastability
Virus particles have to be metastable, which means that they are stable outside the cell to deliver and protect the genetic payload, but unstable inside the cell to release the genome.

Tags:
Source:
Virology
Metastability Activation
In order for a virus to become unstable and release the payload, it has to get from the energetically stable state (1) over the potential hill (2) to the energetically unstable state (3), which is facilitated by a binding receptor.

Tags:
Source:
Virology
Stability Achievement
Metastability is achieved by a symmetrical arrangement of many identical proteins to provide maximum contact. This results in many non-covalent bonds forming between the proteins holding the structure together.
Tags:
Source:
Virology
Electron Microscope
Helmuth Ruska used an electron microscope to take the first picture of a virus in 1940. These are bacteriophages attaching to a bacterium.

Tags:
Source:
Virology
Electron Microscopy Principle
Biological materials have little inherent contrast. They need to be stained. Negative staining is done using electron-dense materials. These allow the microscope to "see" an electron "shadow" of the particle. Resolution: 5.0-7.5 nm (alpha helix is ~1 nm in diameter), so can't see detailed structure.

Tags:
Source:
Virology
X-Ray Crystallography
X-Ray crystallography is high resolution enough (0.2-0.3 nm) to resolve the structure of a virus. Resolves all aminoacids, polypeptide chains, etc. The virus has to be in a crystal form.

Tags:
Source:
Virology
Cryo-electron Microscopy
Instead of crystallizing a virus for regular electron microscopy, this technique rapidly freezes the particle before taking images from different angles and reassembling them into a 3D model.

Tags:
Source:
Virology
Types of Virus Particle Structure
These are main types of virus particle structure:

Tags:
Source:
Virology
Rules for Virus Self-Assembly
Each unit has identical bonding contacts with its neighbors. Repeated interaction of chemically complementary surfaces at the subunit interfaces naturally leads to a symmetric arrangement. These bonds are usually non-covalent, therefore reversible (needed for metastability).
Tags:
Source:
Virology
HPV Vaccine & Self-Assembly
The self-assembly nature of virus particles is used for HPV vaccine production. A genome from an HPV virus is taken and the part encoding the capsid protein is extracted for replication in yeast. The replicated protein (called VLP - virus like particle) self-assembles into a capsid without the genetic material inside. It's then purified and injected into a patient's body for the immune system to learn to recognize it. The particles are harmless as they don't carry any genome.

Tags:
Source:
